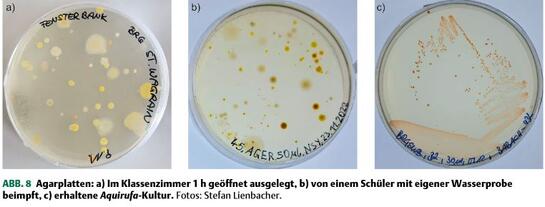
Bakterienkulturen im Sparkling Science Projeekt-Lienbacher

News
2026 · 2025 · 2024 · 2023 · 2022 · 2021 · 2020 · 2019 · 2018 · 2017 ·2016 · 2015 · 2014 · 2013 · 2012 · 2011 · 2010 · 2009 · 2008 · 2007 · 2006 · 2005 · 2004
2023
Frohe Weihnachten und ein erfolgreiches Neues Jahr

Wir freuen uns auf viele, neue Aktivitäten, Kooperationen, Projekte und Ideen, die wir im Jahr 2024 am Forschungsinstitut für Limnologie, Mondsee, umsetzen und hier mit Ihnen teilen können.
online seit, 23.12.2023
Langzeitforschung am Mondsee - Netzwerktreffen
Netzwerktreffen am Forschungsinstitut für Limnologie, Mondsee, Foto: S. Wanzenböck
LTER Seite des Standortes Mondsee
Es waren Vetreter:innen folgender Institutionen beim Netzwerktreffen anwesend:
Bundesamt für Wasserwirtschaft - Institut für Gewässerökologie und Fischereiwirtschaft
Amt der OÖ-Landesregierung - Gewässeraufsicht, hydrographischer Dienst
Bundesforschungszentrum für Wald
Tourismusverband Mondsee-Irrsee
Natura 2000 - Technisches Büro blattfisch
Forschungsinstitut für Limnologie, Mondsee, der Universität Innsbruck
online seit, 06.12.2023
ADVENT - ADVENT
Besuchen Sie unseren Adventkalender und erfahren Sie mehr über die Arbeit und Forschung am Mondsee.
Wir wünschen viel Spaß!
online seit 01.12.2023
Schüler:innen berichten...


Schüler:innen der Mittelschule Mondsee beim Interview von Hans Rund für den Schulpodcast im Sparkling Science Projekt "Biodiversität der Elritzen",
Foto links: Sabine Wanzenböck. Elritzen, Foto rechts: Sylvia K. Wanzenböck
Weitere Aktivitäten und Details zum Projekt sind unter www.elritzen.at abrufbar.
online seit, 24.11.2023
Neue Publikation am ILIM (Mitarbeiterin hervorgehoben)/new publication at ILIM (staff member in bold):
Gogoleva N., Chervyatsova O., Balkin A., Kuzmina L., Shagimardanova E., Kiseleva D., Gogolev Y. (2023). Microbial tapestry of the Shulgan-Tash cave (Southern Ural, Russia): influences of environmental factors on the taxonomic composition of the cave biofilms, Environmental Microbiome 18: 82, https://doi.org/10.1186/s40793-023-00538-1 
In dieser Studie wurde die Shulgan-Tash-Höhle im südlichen Ural, ein Höhlenbiotop, das für einzigartige, paläolithische Malereien berühmt ist, hinsichtlich des Bewuchses von Biofilm untersucht. Höhlenbiotope zeichnen sich generell durch stabile niedrige Temperaturen, hohe Feuchtigkeit und einen Mangel an organischen Substraten aus. Trotz dieser Bedingungen dienen sie mikrobiellen Gemeinschaften als Lebensraum. Ziel der Untersuchung war es die Vielfalt, die Verteilung und die möglichen Auswirkungen dieser Biofilme auf die paläolithischen Malereien der Höhle zu untersuchen und gleichzeitig zu erforschen, wie Umweltfaktoren die mikrobiellen Gemeinschaften in der Höhle beeinflussen. Die Forscher:innen konnten feststellen, dass die Artenzusammensetzung dieser Biofilme die Veränderungen der Umweltbedingungen, wie Substratzusammensetzung, Temperatur, Feuchtigkeit, Belüftung und CO2-Gehalt, widerspiegelt. Die intensive Auflösung und Ablagerung von Karbonaten, die durch Actinobakterien verursacht wird, stellt eine potenzielle Gefahr für die Erhaltung der alten Felsmalereien in der Höhle dar.
Die Publikation ist als Open Access frei zugänglich.
online seit 21.11.2023
Veranstaltungstipp: Vortrag in Traunkirchen am 7.12.2023
Was sind invasive Arten? Welche Auswirkungen haben sie auf unser Ökosystem und wie kann man ihrer Ausbreitung entgegenwirken?
Wir freuen uns auf Ihren Besuch!
Beitrag in 3sat - Forschung am Mondsee
Algen als Wunderwuzzi
Bei der vom BMK initiierten und von der ÖGUT in Kooperation mit BEST - Bioenergy and Sustainable Technologies GmbH durchgeführten Veranstaltung "Netzwerk Algen" werden jährlich der Stand von Forschung, Entwicklung und Innovation hinsichtlich Algen in Österreich mit Fachleuten diskutiert. 2023 wurden unter dem Thema "Wunderwuzzi Algen: von der Hautcreme bis zur Batterie" wissenschaftliche Fachvorträge aber auch angewandte Beiträge im Wiener ZOOM Kindermuseum präsentiert. Das FFG Talente regional Projekt "geniALGE-Algentechnologie als Zukunftshoffnung" bereicherte auf persönliche Einladung ebenfalls das Programm. Im passenden Rahmen wurde dem Fachpublikum das erfolgreiche Algenprojekt mit einem Kurzvortrag und einem Poster vorgestellt, in dem mehr als 800 Kinder und Jugendliche für Mikroalgen begeistert werden konnten. Schon beim letzten Netzwerk Algen-Treffen im Jahr 2022 konnten zwei Schülerinnen der HBLA Ursprung ihre vorwissenschaftliche Arbeit (VWA), die im Projekt entstanden war, mit einem Poster vorstellen. Das Projekt konnte Ende 2022 abgeschlossen werden. Zwei weitere Schülern der HBLA Ursprung haben die Entwicklung und den Bau eines geniALGE-Algenreaktors in ihren VWAs auch noch nach Abschluss des Projekts zum Inhalt.
online seit 03.11.2023
WIRTUNWAS - Schülerinnen und Schüler aus Mondsee, Wien und Tirol packen bei der Forschung mit an
In der Septemberausgabe der Zeitschrift "Wirtunwas" ist ein Artikel über unser aktuelles Sparkling Science Projekt "Kleine Fische ganz groß - Biodiversität der Elritzen in Österreich" erschienen. Das Naturhistorischen Museum Wien und das Forschungsinstitut für Limnologie in Mondsee sind dabei Projektpartner. Schülerinnen und Schüler der Mittelschule Mondsee sind in das Projekt mit Exkursionen, Laborworkshop, Schulpodcast und anderen Aktivitäten eingebunden.
Zur Septemberausgabe der Zeitschrift
online seit, 18.10.2023
Neue Publikation am ILIM (Mitarbeiter hervorgehoben)/new publication at ILIM (staff member in bold):
Melekhin M., Potekhin A., Gentekaki E., Chantangsi C. (2023). Paramecium (Oligohymenophorea, Ciliophora) diversity in Thailand sheds light on the genus biogeography and reveals new phylogenetic lineages, J. Eukaryot. Microbiol. 00:e13004, https://doi.org/10.1111/jeu.13004 
Wimpertierchen der Gattung Paramecium sind als Modellorganismen für die Untersuchung der Biogeografie gut geeignet. Die bisher sehr umfangreichen Probenahmen, hauptsächlich in der nördlichen Hemisphäre, haben zu 16 gültigen morphologischen Artbeschreibungen geführt.
In der vorliegenden Studie wurden auch schwer zugängliche Regionen, einschließlich Südostasien, durch kombinierte traditionelle sowie morphologische und molekulare Ansätze untersucht. So konnten neue Informationen zur Biodiversität von Paramecium in Thailand anhand von mehr als 110 Proben aus 10 Provinzen gewonnen werden. Außerdem wurde eine Vielzahl von bakteriellen, zytoplasmatischen Symbionten aus mindestens neun monoklonalen Kulturen von Paramecium dokumentiert.
online seit, 18.10.2023
Neue Publikation am ILIM (Mitarbeiter:innen hervorgehoben)/new publication at ILIM (staff members in bold):
Stelzer C.-P., Pichler M., Stadler P. (2023). Genome streamlining and clonal erosion in nutrient-limited environments: a test using genome-size variable populations, Evolution, https://doi.org/10.1093/evolut/qpad144

Chemostatkultur, Foto: S. Wanzenböck, ILIM
In dieser Studie wurden Populationen von Rädertieren (Rotatorien) mit unterschiedlichen Genomgrößen der Selektion in einer Chemostat-Kultur ausgesetzt. Hauptziel war es, die Auswirkungen der genetischen Zusammensetzung der Ausgangspopulation und der Phosphorbeschränkung auf die Intensität der Selektion zu bewerten, die als Rate der klonalen Erosion quantifiziert wird. Auch alle phänotypischen Veränderungen in den entstandenen Populationen, einschließlich der Veränderungen in ihrer GS-Verteilung und jegliche phänotypische Anpassung an die Chemostatbedingungen, wurden berücksichtigt. Die Ergebnisse deuten darauf hin, dass die Populationen einen schnellen evolutionären Wandel durchliefen, der nur wenige Wochen dauerte und zu besser angepassten Populationen führte.
Zusammenfassend lässt sich sagen, dass die Genomgröße bei Rädertieren mit kleinem bis mittlerem Genom nur eine begrenzte Auswirkung auf die Klonfitness hat, während sie sich bei Rädertieren mit größerem Genom negativ auf die Wirtsfitness auswirken kann. Die Populationen zeigten auch rasche evolutionäre Veränderungen durch klonale Selektion, was zu einer besseren Anpassung an die neue Umgebung führte. Der Verlust an klonaler Vielfalt im Laufe der Zeit, der als klonale Erosion bezeichnet wird, wurde weitgehend durch die genetische Ausgangszusammensetzung der Population bestimmt. Insgesamt wirft diese Forschung ein neues Licht auf die Evolution der Genomgröße und bietet einen neuen Rahmen für das Verständnis des Zusammenspiels zwischen nukleotypischen und genotypischen Faktoren in diesem Prozess.
Die Finanzierung dieser Studie wurde vom FWF im Rahmen zweier Forschungsprojekte gefördert.
online seit, 10.10.2023
Brand aus am Forschungsinstitut für Limnologie, Mondsee

Die Verwendung des Feuerlöschers wurde praktisch geübt, Foto: S. Wanzenböck, ILIM
Am 9.10.2023 bekamen die Mitarbeiter: innen des Forschungsinstituts Nachhilfe in Sachen Feuerbekämpfung. Die Verwendung einer Löschdecke und die Nutzung verschiedener Feuerlöschertypen wurden geübt. In der Hoffnung, dass dieses Wissen nie zum Einsatz kommen wird, vermittelt es den Mitarbeiter:innen ein Gefühl der Sicherheit zu wissen, was bei einem Brand zu tun ist und welche Hilfsmittel wann verwendet werden sollen. Was viele nicht wussten: Diese Maßnahme ist laut ArbeitnehmerInnenschutzgesetz gesetzlich vorgeschrieben.
online seit, 10.10.2023
Neue Publiation am ILIM/new publication at ILIM:
Dokulil M.T., Teubner K. (2023). Long-term adjustment of phytoplankton structure to environmental traits at timescales during lifetime development and over generations. Hydrobiologia https://doi.org/10.1007/s10750-023-05365-6

Probenahme mit dem Planktonnetz am Mondsee, Foto: ILIM
Über mehr als 60 Jahre wurden ökologische Daten zum Phytoplankton des Mondsees erhoben. Die Autoren stellen fest, dass Phytoplanktongruppen mit unterschiedlichen phänologischen Eigenschaften gut geeignet sind, um die Auswirkungen der beiden Umweltstressoren Nährstoffüberschuss durch Eutrophierung von 1968 bis 1998 und die Erwärmung durch den Klimawandel nachzuweisen. In der vorliegenden Publikation lag der Fokus auf dem Biovolumen, der Artengemeinschaft, den Nettoveränderungsraten und der Biodiversität des Phytoplanktons im Mondsee.
Schlüsselarten, wie die Cyanobakterie Planktothrix rubescens werden als omnipotente Akteure in Phytoplanktongemeinschaften angesehen, weil sie unter verschiedenen Umweltbedingungen langfristig auftreten können und daher für die ökologische Langzeitforschung von großer Bedeutung sind. Die Ergebnisse deuten darauf hin, dass Phytoplanktonarten ausgezeichnete Organismen sind, um die Auswirkungen von Umwelteinflüssen aufgrund ihrer kurzen Generationszeit, ihrer lebenslangen Anpassung und des Vorkommens im Langzeitverlauf über Generationen zu erheben.
Dieser Artikel ist als Open Access Publikation erschienen.
online seit 20.09.2023
Neue Publikation am ILIM/new publication at ILIM:
Carrea L., Merchant C.J., Creatux J.-F., Dokulil T.M., Dugan H.A., Gibbes B., Laas A., Leibensberger E.M., Maberly S., May L., Matsuzaki S.-I., Monet G., Pierson D., Pulkkanen M., Rusanovskaya O.O., Shimaraeva S.V., Silow E.A., Schmid M., Timofeyev M.A., Verburg P., Woolway R.I. (2023). Lake surface water temperature, S28-S30 in: Special Supplement to the Bulletin of the American Meteorological Society 104(9) https://doi.org/10.1175/2023BAMSStateoftheClimate.1 
Das vorliegende Kapitel über die Seeoberflächentemperaturen, in dem auch Daten aus dem Mondsee einfließen, wurde in der bereits 33. Ausgabe der jährlichen Bewertung, die seit 1996 im Bulletin of the American Meteorological Society veröffentlicht wird und jetzt als State of the Climate bekannt ist, veröffentlicht. Der Bericht wird der von den Nationalen Zentren für Umweltinformationen (NOAA) erstellte und basiert auf Beiträgen von Wissenschaftler:innen aus der ganzen Welt. Er bietet einen detaillierten Überblick über globale Klimaindikatoren, bemerkenswerte Wetterereignisse und andere Daten, die von Umweltüberwachungsstationen und -instrumenten auf dem Land, im Wasser, im Eis und im Weltraum gesammelt wurden. Als Ergänzung zum Bulletin, dient er in erster Linie dazu, den Zustand und die Entwicklung vieler Komponenten des Klimasystems zu dokumentieren. Der Bericht dokumentiert jedoch auch den Status und die Entwicklung der eingesetzten Kapazitäten und des weltweiten Engagements um das Klimasystem zu beobachten.
online seit 18.09.2023
Masterstudium abgeschlossen

Josef Wanzenböck, Aylin Olgun, Dunja Lamatsch und Claus-Peter Stelzer bei der Gratulation (v.l.n.r.), Foto. S. Wanzenböck, ILIM
Heute, 15.09.2023, hat Aylin Olgun ihre Verteidigung der Masterarbeit "Population-genetic structure of Austrian Carassius spp. populations and their artificially bred F1 and F2 offspring" erfolgreich abgeschlossen. Sie wurde dabei von Dunja Lamatsch und Josef Wanzenböck am Forschungsinstitut für Limnologie in Mondsee betreut und geprüft. Als Vorsitzender der Verteidigung fungierte Claus-Peter Stelzer.
Aylin Olgun hat in ihrer Masterarbeit vor allem den Giebel, eine der invasivsten Fischarten, aber auch die einheimische Karausche untersucht. Dabei konnte sie teilweise auf Wildfänge als auch auf Fische, die schon in den hauseigenen Aquarienräumen zu Untersuchungszwecken gehalten worden waren, zurückgreifen. Interessant ist die Fähigkeit des Giebels sich sowohl sexuell, als auch asexuell fortzupflanzen. Das Giebelweibchen nutzt dabei das Sperma von Männchen der gleichen Familie nur zur Anregung der Eizelle zur Teilung. Das genetische Material der artfremden Männchen wird aber nicht verwendet. Das Giebelweibchen bringt in der Folge Klone zur Welt, die sich auch wieder ungeschlechtlich oder geschlechtlich fortpflanzen können. Diese Strategie ermöglicht die enorm rasche Ausbreitung der Art und die Gefährdung der ursprünglich im gleichen Lebensraum vorkommenden Karausche.
Aylin Olgun hat verschiedene Giebelpopulationen aus ganz Österreich untersucht und festgestellt, dass Hybride zwischen Giebel und Karausche nur dann fertil waren, sich also wieder fortpflanzen konnten, wenn das Weibchen der Giebel und das Männchen die Karausche war. Bei anderen Kombinationen der Eltern konnten sich die Jungen nicht mehr reproduzieren.
Aus ihren Ergebnissen konnte sie auch eine 2n-Population (mit diploidem Chromosomensatz) aus dem Neusiedlersee als möglicherweise während der Eiszeit isolierte Population identifizieren. Die anderen untersuchten Populationen aus Österreich waren entweder triploid oder tetraploid. Als Analysemethoden hat sie Mikrosatelliten und die Flowzytometrie verwendet.
Wir gratulieren Aylin zum erfolgreichen Abschluss ihrer interessanten Arbeit, die weitere Forschungsfragen aufwirft.
online seit, 15.09.2023
Neue Publikation am ILIM (MitarbeiterInnen hervorgehoben)/new publication at ILIM (staff members in bold):
Purker, M., Dobrovolny S. , Kreuml M. , Hufnagl P. , Indra A. , Kurmayer R. (2023). Quantitative relationships among high-throughput sequencing, cyanobacteria toxigenic genotype abundance and microcystin occurrence in bathing waters, Science of The Total Environment 901:165934 https://doi.org/10.1016/j.scitotenv.2023.165934
Toxinproduzierende Cyanobakterien (Blaualgen) in Badegewässern können eine erhebliche Bedrohung für die Gesundheit von Mensch und Tier darstellen. Um die öffentliche Gesundheit besser zu schützen und die Gesundheitsrisiken während der Badesaison zu verringern, ist eine wirksame Überwachungs- und Bewirtschaftungsstrategie erforderlich. In der vorliegenden Studie wurden molekulare Instrumente zur Überwachung giftbildender Cyanobakterien bewertet um eine Frühwarn-Überwachungsstrategie für Badegewässer in der EU einzurichten. Weiters soll das toxische Potenzial von Cyanobakterien mit dem tatsächlichen Vorkommen und der Konzentration von Microcystin (kleine Eiweißstoffe, die enzymhemmende Eigenschaften aufweisen und eine toxische Wirkung haben) verglichen werden. Zu diesem Zweck wurden 16 Badegewässerstandorte gemäß der Badegewässerrichtlinie (BWD) der Europäischen Kommission überwacht.
Für die Analysen kamen zwei Methoden zum Einsatz:
Die Hochdurchsatz-Sequenzierung (HTS), die die parallele Sequenzierung von mehreren DNA-Abschnitten in einem Durchgang ermöglicht und die quantitative oder Echtzeit PCR, bei der fluoreszierende Moleküle verwendet werden, die sich an die DNA binden. Die Fluoreszenz der Probe steigt proportional zur Anzahl der DNA-Moleküle an.
Durch die Kombination der beiden Methoden wurde Microcystin am zuverlässigsten vorhergesagt. Daher wird der Einsatz von HTS- und qPCR-Techniken in Kombination mit der Überwachung von Standard-Umweltparametern HTS- und qPCR-Techniken als äußerst nützlich angesehen, um die rechtzeitige Erkennung von Gesundheitsrisiken für realen Nutzern zu gewährleisten, wie dies von der BWD gefordert wird.
Die Arbeit wurde von der Österreichischen Agentur für Gesundheit und Ernährungssicherheit (AGES), Mitteln aus dem EU-Interreg Alpine Space Projekt "Eco-AlpsWater" und Fördermitteln aus dem FWF Projekt SLOT finanziert.
online seit, 10.08.2023
Neue Publikation am ILIM (MitarbeiterInnen hervorgehoben)/new publication at ILIM (staff members in bold):
Pitt A., Hahn M. (2023). Wissen schaffen mit Citizen Scientists: Biodiversität und Ökologie von Süßwasserbakterien. Biologie in unserer Zeit, 53(3): 272–279. https://doi.org/10.11576/biuz-6525
Abbildung aus der Publikation
Die Einbindung von Citizen Scientists in wissenschaftliche Forschung wird in dieser Veröffentlichung anhand zweier Sparkling Science Projekte erläutert. Schülerinnen und Schüler unterstütz(t)en Mondseer Forschende aus dem Bereich Umweltmikrobiologie bei der Suche und Bestimmung von Süßwasserbakterien und waren bereits in die Namenssuche neu gefundener Arten eingebunden. Neben der Vermittlung der Bedeutung von Süßwasserbakterien für Gewässerökosysteme, konnten in diesen Projekten bereits zahlreiche wissenschaftliche Publikationen dem immer höheren Anspruch von Citizen Science Projekten gerecht werden. Damit profitieren sowohl die beteiligten Wissenschafterinnen und Wissenschafter als auch die Cititzen Scientists von der Zusammenarbeit.
Die Publikation wurde vom BMBWF gefördert und ist online frei zugänglich.
online seit 09.08.2023
Bundespräsident Alexander van der Bellen besuchte Forschungsinstitut für Limnologie in Mondsee
Dekan Paul Illmer, Doris Schmidauer, Bundespräsident Alexander van der Bellen,
Institutsleiter Otto Seppälä, Foto: Sabine Wanzenböck
Fotogalerie zum Besuch ILIM, Fotos: S. Wanzenböck
Fotogalerie zum Besuch offiziell, Fotos: P. Lechner/HBF
Bundespräsident Alexander Van der Bellen hat am 28.07.2023 das Forschungsinstitut für Limnologie der Universität Innsbruck in Mondsee (OÖ) besucht. Dabei führte er u.a. Gespräche mit Forscher:innen zu Auswirkungen der Klimakrise auf Österreichs Seen. Acht Forschungsgruppen widmen sich am Institut in Mondsee der Erforschung von See-Ökosystemen und der Evolution von Organismen in einer sich ändernden Umwelt. Der Bundespräsident hat sich von den Forscher:innen am Mondsee u.a. über die Auswirkungen der Klimakrise auf Österreichs Seen informieren lassen. „Mit ihren Forschungsergebnissen und ihren Erkenntnissen zur Auswirkung der Klimakrise, leisten das Institut und seine Mitarbeiterinnen und Mitarbeiter einen wichtigen Beitrag zum Schutz von Österreichs Gewässern. Damit wir unsere Seen auch für kommende Generationen erhalten und gesund halten können“, betonte der Bundespräsident.
Wie passen sich Seebewohner an klimatische Veränderungen sowie zunehmende menschliche Eingriffe an und welche Auswirkungen hat das auf Ökosysteme? Unter anderem diesen Fragen gehen die Mitarbeiter:innen des Instituts unter der Leitung von Otto E. Seppälä in ihrer evolutionsökologischen Forschung nach. Sie gaben Van der Bellen Einblick in ihre Arbeit: Mit Hilfe von Bakterien, Planktonorganismen, Algen, Schnecken, Fischen, etc. werden am Mondsee Muster und Prozesse ökologischer und evolutionsbiologischer Relevanz untersucht. Die Auswertung von Langzeitdaten zur Limnologie im Mondsee und weiteren Seen in verschiedenen Höhenlagen sollen ein vollständiges Bild der Ökologie der heimischen Seen ergeben – wichtige Erkenntnisse für die Grundlagenforschung, die aber auch für den Schutz der heimischen Gewässer und das Gewässermanagement von Bedeutung sind. Die Universität Innsbruck war beim Besuch auch durch Paul Illmer, den Dekan der Fakultät für Biologie, vertreten.
In einem Übersichtsvortrag stellte Dekan Paul Illmer die Fakultät für Biologie der Universität Innsbruck vor. Während einer Fahrt mit dem Forschungsboot auf dem Mondsee präsentierten Wissenschafter:innen des Instituts Freilandmethoden und Daten zur aktuellen Situation des Mondsees. An fünf Stationen vermittelten Studierende aus verschiedenen Forschungsgruppen des Instituts Methoden und eigene Ergebnisse zu den Themen UmweltDNA-Analyse zur Bestimmung von Fischarten, Pigmente von Cyanobakterien/Blaualgen und ihre Nutzung bei Gewässeruntersuchungen, Biodiversität von Ciliaten/Wimpertierchen und ihre Nutzung als Bioindikatoren, Problematik der invasiven Arten am Beispiel der Fischart Giebel.
online seit 28.07.2023
Internationaler Workshop zur Ökologie von Ciliaten am Mondsee
NGTax-Gruppenbild, Foto: V. Trifinov
Im Rahmen des EU Projekts Next Generation Taxonomy: Ciliophora and their bacterial symbionts as a proof of concept (NGTax) - EU - Horizon 2020 Marie Curie Actions fand zwischen 17. und 21. Juli 2023 der Ciliate Ecology Workshop - Next Generation Taxonomy am Forschungsinstitut für Limnologie, Mondsee, statt. In Vorträgen und Freiland- sowie Laborworkshops wurden die internationalen Teilnehmer:innen von der Forschungsgruppenleiterin Bettina Sonntag und ihrem internationalen Team betreut.
Im Programm wurden Themen wie die Biodiversität und Ökologie der Ciliaten im Seeplankton und Biofilm, die Diversität, Bestimmung und Kultivierung von Algen- und Bakterienendosymbionten, sowie die Funktion von Ciliaten als Bioindikatoren für die Bestimmung der Wasserqualität behandelt.
Tagung der Europäischen und Internationalen Gesellschaften für Protistologie
Der Workshop in Mondsee fand im Anschluss an die Internationale und Europäische Tagung für Protozoologie (ECOP-ISOP) in Wien statt, bei der Mitarbeiter:innen des Forschungsinstituts für Limnologie, Mondsee, im Organisationsteam mitarbeiteten und Wissenschafter:innen aus Mondsee zahlreiche, wissenschaftliche Beiträge präsentierten. Der Kongress der Europäischen Gesellschaften ist die wichtigste Veranstaltung der Federation of European Protistological Societies (FEPS), die alle vier Jahre stattfindet. Die Tagung wurde von der Fakultät für Biologie der Universität Innsbruck finanziell unterstützt.
ECOP-ISOP Gruppenbild Wien, Foto: S. Wickham
online seit, 24.07.2023
Puzzlestück zur Geburtenkontrolle bei invasiver Fischart entdeckt

Moskitofischweibchen, Foto: M. Pichler
Einem internationalen Forschungsteam unter der Leitung von Dunja Lamatsch vom Forschungsinstitut für Limnologie, Mondsee, der Universität Innsbruck ist es gelungen, das W-Geschlechtschromosom des weiblichen Moskitofischs auf molekularer Ebene zu entschlüsseln. Damit könnte in Zukunft die Ausbreitung dieser äußerst invasiven Fische gebremst werden. Mehr im Newsroom der Universität Innsbruck unter https://www.uibk.ac.at/de/newsroom/2023/puzzlestuck-zur-geburtenkontrolle-bei-invasiver-fischart-entdeck/
online seit 12.07.2023
Neue Publikation am ILIM (Mitarbeiter:innen hervorgehoben)/new publication at ILIM (staff members in bold):
Schirpke U., Ebner M., Fontana V., Enigl K., Ohndorf M., Pritsch H., Kurmayer R. (2023). Climate response of alpine lakes and impacts on ecosystem services, Landscape Online 98: 1109, doi:10.3097/LO.2023.1109
. https://landscape-online.org/index.php/lo/article/view/LO.2023.1109
Globale Erwärmung und menschlicher Einfluss sind Faktoren, die die ökologische Integrität kleiner Alpenseen stark beeinflussen können. Im interdisziplinären Projekt CLAIMES (CLimate response of AlpIne lakes: resistance variability and Management consequences for Ecosystem Services) wurden neben den limnologischen Daten und der Modellierung der Oberflächentemperatur auch die potentiellen Auswirkungen auf die damit verbundenen Ökosystemleistungen an 15 Seen in den Niederen Tauern (Österreich) und Südtirol (Italien) untersucht. Die priorisierten Ökosystemleistungen wurden anhand mehrerer Indikatoren quantifiziert, und die potenziellen künftigen Auswirkungen wurden auf der Grundlage verschiedener möglicher Worst-Case-Szenarien bewertet.
Unsere Ergebnisse zeigen, dass die globale Erwärmung die die Dauer der Eisbedeckung verringert, was sich auf die Ökosystemfunktionen und folglich auf den trophischen Zustand auswirken wird. Die Ergebnisse zeigen auch, dass die Bereitstellung von Ökosystemleistungen durch Seen weitgehend von den lokalen sozio-ökologischen Merkmalen beeinflusst wird. Der prognostizierte Rückgang der Ökosystemleistungen in der Zukunft erfordert eine bessere Integration der Ökosystemleistungen alpiner Seen in die Entscheidungs- und Politikgestaltung auf verschiedenen Verwaltungsebenen.
online seit 07.07.2023
Neue Publikation am ILIM (Mitarbeiter hervorgehoben)/new publication at ILIM (staff member in bold):
Seppälä O., Schlegel T. (2023). Substrate specificity of phenoloxidase-like activity in an ecoimmunological model species Lymnaea stagnalis, Journal of Molluscan Studies 89(1): eyad005, https://doi.org/10.1093/mollus/eyad005 
Um die Stärke der Immunfunktion von Schnecken gegenüber verschiedenen Umweltfaktoren, wie z.B. Temperaturveränderungen oder chemischen Verschmutzungen in Gewässern abschätzen zu können, wird in der Forschung die Aktivität von Phenoloxydase-Enzymen (PO) in der Hämolymphe untersucht. In der vorliegenden Studie wurden diese Enzyme und deren Stärke der oxidativen Reaktionen bei der Spitzschlammschnecke Lymnaea stagnalis, einer in Österreich verbreiteten, heimischen Süßwasserschnecke, analysiert. Wirbellose Tiere (und damit auch Schnecken) verfügen über drei PO-Aktivitäten, aber ihre relative Rolle bei oxidativen Reaktionen ist in der Regel unbekannt. Dies liegt daran, dass die PO-Aktivität meist mit L-Dopa (o-Diphenol, das von allen PO-Enzymen oxidiert wird) als Substrat quantifiziert wird. Das Verständnis der relativen Bedeutung der verschiedenen PO-Enzyme könnte jedoch von großem Nutzen sein. Die Ergebnisse der Studie regen dazu an, die Rolle der verschiedenen PO-Enzyme bei der Bestimmung der PO-Aktivität bei verschiedenen ökologisch-immunologischen Modellarten zu untersuchen, um die Forschung durch verbesserte PO-Tests zu stärken.
online seit 07.07.2023
Neue Publikation am ILIM (MitarbeiterInnen hervorgehoben)/new publication at ILIM (staff member in bold):
Fokin S.I., Lebedeva N.A., Potekhin A., Gammuto L., Petroni G., Serra V. (2023). Holospora-like bacteria “Candidatus Gortzia yakutica” and Preeria caryophila: Ultrastructure, promiscuity, and biogeography of the symbionts. European Journal of Protistology 90: 125998, https://doi.org/10.1016/j.ejop.2023.125998 
Es ist bekannt, dass Bakterien der Familie Holospora im Zellkern von Wimpertierchen der Gattung Paramecium leben können. Diese Bakterien müssen als Parasiten betrachtet werden, auch wenn die Wimpertierchen durch den erfolgten Stress nach dem Befall besser gegen negative Umweltweinflüsse wie erhöhte Salinität oder Temperaturanstieg gewappnet sind. In der vorliegenden Studie konnten zwei Holospora-ähnliche Bakterienarten "Candidatus Gortzia yakutica" in den neuen Wirten Paramecium nephridiatum bzw. Paramecium polycaryum gefunden werden. Die bisherige Annahme der Wirtsspezifität der Bakterienarten muss damit kritisch betrachtet werden und wird unter biogeographischen und ökologischen Gesichtspunkten diskutiert.
online seit 26.06.2023
Neue Publikation am ILIM (Mitarbeiter hervorgehoben)/new publication at ILIM (staff members in bold):
Pritsch H., Schirpke U., Jersabek C.D., Kurmayer R. (2023). Plankton community composition in mountain lakes and consequences for ecosystem services, Ecological Indicators 154: 110532, https://doi.org/10.1016/j.ecolind.2023.110532 
Bergseen bieten eine Vielzahl von Ökosystemleistungen (ES) wie Wasser, Lebensraum, Erholung und ästhetische Werte. Durch unterschiedliche Einflüsse geraten diese Seen immer mehr unter Druck. Die Entwicklung geeigneter Indikatoren zur Überwachung von Veränderungen der ES soll bei der Planung gezielter Schutzmaßnahmen helfen. Als Grundlage dafür sind auch limnologische Daten erforderlich. In dieser Studie wurde, neben den weit verbreitete Standardparametern, die genetische Untersuchung des Phytoplanktons mittels Metabarcoding auf der Grundlage von 16S/18S rDNA-Hochdurchsatzsequenzierung (HTS) verwendet. Die Ergebnisse der Untersuchung deuten darauf hin, dass eine Verschlechterung der ökologischen Bedingungen in Bergseen die künftige Bereitstellung von ES negativ beeinflussen könnte. Daher wird es immer wichtiger, unberührte Seen zu schützen, wobei Daten über die Zusammensetzung der Planktongemeinschaft nützliche Anhaltspunkte für die Entscheidung liefern können, welche Seen vorrangig durch geeignete Maßnahmen geschützt werden sollten.
Die Publikation entstand im Earth System Sciences (ESS 2018) Programm "Water in Mountains", Projekt CLAIMES (Climate response of alpine lakes: resistance variability and management consequences for ecosystem services): https://www.uibk.ac.at/projects/claimes/ finanziert durch das Bundesministerium für Bildung, Wissenschaft und Forschung durch die Österreichische Akademie der Wissenschaften (ÖAW) und ist Teil der Doktorarbeit von Hanna Pritsch am Forschungsinstitut für Limnologie, Mondsee, der Universität Innsbruck (Betreuung: R. Kurmayer).
online seit 23.06.2023
Schulpodcast zum Sparkling Science Projekt "Biodiversität der Elritzen" und Freilandexpedition mit der Mittelschule Mondsee
Interview von Hans Rund für den Schulpodcast im Sparkling Science Projekt (links), Uferzugnetzfang mit den Schüler:innen am Mondsee (rechts), Fotos: S. Wanzenböck
Im Projekt "Kleine Fische ganz groß - Biodiversität der Elritzen in Österreich", das im Rahmen von Sparkling Science gefördert wird, arbeiten Wissenschafter:innen des Naturhistorischen Museums Wien und des Forschungsinstituts für Limnologie, Mondsee, gemeinsam mit Schulen in Wien, Schladming, Mondsee und Innsbruck zusammen. Die Mittelschule Mondsee hat zum Projekt den ersten Schul-Podcastbeitrag erstellt, der nun unter #6 "Kleine Fische ganz groß - Biodiversität der Elritzen Österreichs" (Citizen Science Project) - Schooltalk der Mittelschule Mondsee | Podcast on Spotify abrufbar ist. Darin erklären die Projektmitarbeiter Hans Rund und Sabine Wanzenböck, die Grundlagen des Projekts, die Vorteile für Wissenschaft und Schulen, sowie die geplanten Aktivitäten. Zurzeit arbeiten die Schüler:innen der Mittelschule Mondsee bereits am zweiten Podcastbeitrag zum Projekt.
Die erste Freilandbeprobung im Rahmen des Projekts fand am 22.06.2023 mit der ersten Klasse der Mittelschule Mondsee statt.
Nach mehreren theoretischen Teilen ging es nun ins Freiland. Ausgerüstet mit Kanister, Handschuhen und Uferzugnetz, nahmen die Schüler:innen unter Anleitung der Projektmitarbeiter vom Forschungsinstitut für Limnologie, Mondsee, Proben am Zellerbach, der Fuschler Ache und am Mondsee. Ziel der Aktion war es festzustellen, ob in den Wasserproben die Erbsubstanz (DNA) einer gefährdeten Kleinfischart, der Elritze, zu finden ist. Akribisch wurden von den Kindern Protokollblätter mit wichtigen Daten an den Probestandorten ausgefüllt. Dabei lernten die Schüler:innen limnologische Arbeitsmethoden im Freiland kennen. Biotische und abiotische Parameter wurden mit einer Sonde gemessen und als Höhepunkt kam das Uferzugnetz zum Einsatz. Dadurch konnten die Schüler:innen erstmals Elritzen in ihrem Lebensraum kennenlernen. Im Labor wurden die Wasserproben gemeinsam durch Spezialfilter filtriert und für die DNA-Analyse vorbereitet. Wir sind schon auf die Ergebnisse gespannt!
online seit 23.06.2023
Helfen Sie mit – Auf der Suche nach der Spitzschlammschnecke!

Spitzschlammschnecken (Lymnaea stagnalis), Foto: O. Seppälä
Sie haben einen Gartenteich, Sie bewegen sich gerne in der Natur und wollen sich bei einem Forschungsprojekt beteiligen? Dann helfen Sie uns bei der Suche nach einer einheimischen Süßwasserschneckenart, der Spitzschlammschnecke (Lymnaea stagnalis), die ausschließlich im Wasser lebt!
Die Spitzschlammschnecke wird von Parasiten infiziert, die für den Menschen ungefährlich sind. Wir wollen in unserer Forschung herausfinden, wie sich sommerliche Hitzewellen auf die Schnecken und ihre Parasiten auswirken.
Wir haben dazu einen Fragebogen entwickelt und ersuchen Sie um Ihre Unterstützung zur Sammlung von wichtigen Daten für die Forschung in Österreich und im Raum Bayern. Dazu sollen die Schnecken NICHT aus dem Gewässer entnommen werden! Bitte füllen Sie den Erhebungsbogen aus und senden ihn mit Fotografien der Fundstelle an: snailpop2023@gmail.com
Vielen Dank für Ihre Unterstützung bei der Erhebung von Forschungsdaten!
online seit 20.06.2023
Girls´ Academy - Workshops zum Einblick in MINT Berufe


Im Genetikworkshop wurde die Erbsubstanz extrahiert (links) und im Mikroskopierworkshop konnten die Schülerinnen die
mikroskopische Biodiversität im See kennenlernen (rechts), Fotos: Sabine Wanzenböck
Die Geschlechterausgewogenheit in Mathematik-Informatik-Naturwissenschaften-Technik (= MINT) Berufen lässt immer noch zu wünschen übrig. Daher soll mit dem Projekt "MI(N)Tgestalten" eine "Community of Practice" für mehr Frauen in MINT-Berufen im Salzkammergut aufgebaut werden. Am 14.06.2023 wurden Schülerinnen des BG Schloss Traunsee zum Girls´ Academy-Workshop "Faszination Wasser – Lebensraum für Artenvielfalt und Forschungsobjekt" eingeladen. Dunja Lamatsch und Bettina Sonntag, beide Forschungsgrippenleiterinnen am Forschungsinstitut für Limnologie, Mondsee, gaben an der Schule Einblick in die Gewässer- und Evolutionsforschung. Sabine Wanzenböck informierte über die dazu erforderliche Ausbildung und gab Infos zu Praktikumsmöglichkeiten am Forschungsinstitut in Mondsee. Dieser Workshop ist nur einer einer ganzen Reihe, die im Rahmen der Girls´ Academy in Kooperation mit der Internationalen Akademie Traunkirchen organisierten werden.


Die beiden Forschungsgruppenleiterinnen Dunja Lamatsch und Bettina Sonntag
bei der Girls´ Academy in Altmünster, Fotos: Sabine Wanzenböck
online seit 16.06.2023
Postdoc Position: UInnsbruck.HeatwaveAdaptation
A postdoc position is available in the group of Aquatic Evolutionary Ecology at the University of Innsbruck (Research Department for Limnology, Mondsee), Austria.
In this position, you can experimentally examine the evolutionary ecology of the responses of the freshwater snail Lymnaea stagnalis to changing environmental conditions under climate change.
The specific goals are to evaluate
(1) if natural snail populations are adapted to local temperature conditions that they experience, and
(2) if and how much evolutionary potential exists in their heatwave responses.
The project is linked to other work in the research group focusing on natural selection on and quantitative genetics of heatwave responses of L. stagnalis.
General information about the research group and the institute can be found at https://www.uibk.ac.at/limno/
The Research Department for Limnology is located on the edge of the Alps in the small town of Mondsee (Upper Austria). The nearest city is Salzburg, which offers history, culture and entertainment at a convenient distance from Mondsee.
We invite highly motivated persons with a strong background in evolutionary ecology and experimental research to apply for this position. A PhD degree is required. Earlier experience with the study system is not necessary.
The project is funded by the Austrian Science Fund (FWF) for a maximum of 27 months depending on the starting date. The salary is based on the personnel cost rates of the FWF https://www.fwf.ac.at/en/research-funding/personnel-costs
Start of the project: as soon as possible.
Qualified persons are invited to apply by email. Please attach a single PDF file including a letter of motivation, CV, a research statement (max 2 pages), and names plus contact information of two references to otto.seppaelae@uibk.ac.at. The subject line should read “postdoc 2023”. Evaluation of the applications starts June 16, 2023. Only complete applications are considered. Top candidates will be interviewed.
Prof. Otto Seppälä
online since June 6, 2023
Neue Publikation am ILIM/new publication at ILIM:
Dokulil, M.T. (2023). Die Lunzer Seen – ein wissenschaftlich-historischer Exkurs. Hommage an Prof. Dr. Franz Berger. The Lakes near Lunz, Austria – a science-historic perspective. Homage to Prof. Dr. Franz Berger, Acta ZooBot Austria 159: 229-271.

Abbruch der Biologischen Station in Lunz am See 2010, Foto: S. Wanzenböck
Mit dieser umfangreichen Arbeit präsentiert Martin Dokulil mehr als ein Jahrhundert Forschung an der Biologischen Station
Lunz am See seit 1900. Die Biologische Station in Lunz war, bis 2003, wie auch das Institut für Limnologie in Mondsee, eine Abteilung an der Österreichischen Akademie der Wissenschaften. Das Gebäude der Biologischen Station in Lunz wurde 2010 großteils entfernt und neu adaptiert. Seit 2011 wird das neue Gebäude dort vom WasserCluster Lunz genutzt, an dem die limnologische Forschung am Lunzer See fortgeführt wird.
Martin Dokulil hat in dieser Veröffentlichung bisher unbekannte Daten aus dem wissenschaftlichen Nachlass des legendären Limnochemikers Prof. Dr. Franz Berger mit veröffentlichten Ergebnissen kombiniert und bekannte, aber verstreute Daten zusammengeführt, verglichen und neu interpretiert. Auch Doktorarbeiten und weniger bekannte Veröffentlichungen wurden in die Publikation eingebunden. Mit einem Resümee der historischen Abläufe gibt er einen Hinweis auf künftige Forschungsfragen.
online seit 05.06.2023
Machen Sie beim Citizen Science Projekt Aquirufa mit!


Standorte des Projekt Aquirufa in der Weitwörther Au (links) und am Mondsee (rechts), Fotos: A. Pitt
Am Forschungsinstitut in Mondsee (16.06.2023, 14:00 Uhr) sowie in der Auenwerkstatt in der Weitwörther Au (23.06.2023, 14:00 Uhr) werden im Sparkling Science Projekt Aquirufa: Biodiversität und Ökologie von Süßwasserbakterien (www.sparklingbacteria.com) Workshops für interessierte Bürger/innen stattfinden.
Wir werden gemeinsam (in Mondsee mit dem Boot) Wasserproben nehmen, Messungen durchführen und mit den Proben wie in einem mikrobiologischen Labor arbeiten. Die Teilnehmer/innen erhalten einen Einblick in das wissenschaftliche Arbeiten mit Gewässerbakterien und werden selbst als Citizen Scientists aktiv. Das ist gar nicht schwer, es sind keine Vorkenntnisse nötig und ab ca. 15 Jahren geeignet. Kinder ab ca. 12 Jahren können auch gerne mit einem Erwachsenen gemeinsam teilnehmen. Wer mag, kann nach vorheriger Absprache auch eine Probe aus einem Gewässer (z.B. Gartenteich) mitbringen.
Information und Anmeldung: Alexandra.Pitt@uibk.ac.at
online seit, 30.05.2023
Energy Globe Auszeichnung für Algenprojekt am Mondsee
Verleihung der Auszeichnung für das Projekt geniALGE durch LR Kaineder an das Projekt geniALGE, Foto: Mathias Lauringer (links)
Die Urkunde und die Energy Globe Medaille wurden von Projektleiterin S. Wanzenböck und Projektkoordinatorin M. Ellmauer übernommen,
Foto rechts: Wirtschaftslandesrat M. Achleitner und Landesrat S. Kaineder mit den Projektverantwortlichen
Die Freude war groß: Projektleiterin S. Wanzenböck vom Forschungsinstitut für Limnologie, Mondsee, der Universität Innsbruck konnte für das FFG Talente regional Projekt geniALGE einen Energy Globe Award Preis in der Kategorie Jugend entgegennehmen. Gemeinsam mit Projektkoordinatorin M. Ellmauer vom Technologiezentrum Mondseeland fand die Preisverleihung am 24.05.2023 im ORF Landesstudio OÖ in Linz vor zahlreichen Gästen statt. Danke an alle, die beim Projekt mitgewirkt und uns unterstützt haben, ihnen allen sei dieser Preis gewidmet.
online seit 25.05.2023
Innsbrucker Schule im Rahmen eines Sparkling Science Projekts
zu Besuch am Mondsee
Fotos: S. Wanzenböck, V. Razumov
Interview für den Schulpodcast der MS Mondsee, Foto: S. Wanzenböck
Neue Publikation am ILIM (MitarbeiterInnenhervorgehoben)/new publication at ILIM (staff members in bold):
Müller S., Du K., Guiguen Y., Pichler M., Nakagawa S., Stöck M., Schartl M., Lamatsch D.K. (2023). Massive expansion of sex–specific SNPs, transposon related elements, and neocentromere formation shape the young W-chromosome from the mosquitofish Gambusia affinis. BMC BIOLOGY 21: 109, https://doi.org/10.1186/s12915-023-01607-0 

Gambusia Weibchen, Foto: M. Pichler
In dieser Studie wurden neue Erkenntnisse über die genomische Organisation und Differenzierung von evolutionär jungen Geschlechtschromosomen bei Fischen untersucht und eine solide Grundlage für die weitere Erforschung der funktionellen Bedeutung dieses evolutionären Prozesses geschaffen.
online seit 16.05.2023
Geniale Algen - Kooperationsprojekt bekommt mit Ihrer Hilfe den Energy Globe Award OÖ



Wozu braucht man Algen? Welche Algen gibt es überhaupt? Wie können Algen für Nahrung, Energie und als Rohstoff genutzt werden? Spannende Fragen, die im Projekt geniALGE beantwortet wurden. Jetzt steht das Projekt vor der Preisverleihung für den Energy Globe Award OÖ und Sie können zur Auszeichnung beitragen!
Im FFG Talente regional Projekt "geniALGE - Algentechnologie als Zukunftshoffung" konnten insgesamt 835 Kinder und Jugendliche an spannenden Exkursionen, Workshops, peer-learning Aktivitäten aktiv teilnehmen und mehr zu Forschung Technologie und Innovation erfahren. Sechs Schulen aus der Region waren ins Projekt eingebunden, zehn Kooperationszuschüsse an Kindergärten und Schulen in ganz Österreich konnten vergeben werden, vier vorwissenschaftliche Arbeiten wurden erfolgreich abgeschlossen und bereits mit zwei Preisen ausgezeichnet. Das Projekt wurde von Juli 2020 bis Dezember 2023 vom Forschungsinstitut für Limnologie der Universität Innsbruck in Mondsee geleitet und vom Technologiezentrum Mondseeland koordiniert. Experten und Expertinnen aus Wissenschaft, und Technik begleiteten die Kinder und Jugendlichen während des Projekts. Jetzt bitten die Projektverantwortlichen um Ihre Unterstützung! Mittels Publikumsvoting rittern die nominierten Projekte um die Zuerkennung des Energy Globe Award OÖ 2023. Bis 23. Mai 2023 12:00 Uhr kann auf der Webseite des Energy Globe Awards www.energyglobe.at für das Projekt geniALGE unter https://www.energyglobe.at/voting/forschungsinstitut-fur-limnologie-mondsee-der-universitat-innsbruck abgestimmt werden. Mehrfachabstimmungen werden ermöglicht.
Mehr zum Projekt geniALGE finden Sie unter www.genialge.at und www.instagram.com/geni.alge
Das Projekt wurde von der Forschungsförderungsgesellschaft FFG finanziert.
online seit 12.05.2023
Zwei Masterarbeiten am Mondsee zu vergeben
Wir suchen Bewerber:innen für zwei Masterarbeiten im FWF Projekt "Süßwasser-Ulvophyceae: Biodiversität, Ökologie und Evolution" am Forschungsinstitut für Limnologie, Mondsee (OÖ).
Forschungshintergrund und Hypothese des Projekts:
Phylogenetische Analysen von SSU rRNA Sequenzen haben die Systematik der Viridiplantae revolutioniert.
Das traditionelle Klassifizierung basierend auf Organisationsstufen wurde ersetzt durch ein System, welches
ultrastrukturelle und molekulare Merkmale benutzt. Kokkale und fädige Grünalgen, ursprünglich zu zwei
Ordnungen Chlorococcales und Ulotrichales/Chaetophorales gestellt, sind in allen Klassen der Chlorophyta
(Chlorophyceae, Trebouxiophyceae and Ulvophyceae) verbreitet. Die letztgenannte Klasse enthält meistens
marine Seetange und Mikroalgen. Allerdings haben neue Studien gezeigt, dass auch Süßwasser- und
Bodenalgenarten bei den Ulvophyceae vertreten sind, aber es ist sehr wenig über diese Arten bekannt.
Traditionell gehören diese Arten zu Gattungen der Chloro- oder Trebouxiophyceae. Diese sind aber bislang
nicht taxonomisch revidiert wurden. Vorläufige Untersuchungen zeigten, dass nicht-marine Ulvophyceen in
mindestens fünf unabhängige Linien der Ulvophyceae zu finden sind. Daher ist Diversität dieser Grünalgen
größer als erwartet. Phylogenetische Analysen haben sogar die Monophylie der Ulvophyceae in Frage
gestellt und macht ein neues Klassifikationssystem notwendig, um die Phylogenie dieser sehr diversen
Gruppe der Grünalgen zu klären.
Wir möchten vier Hypothesen prüfen, um die Monophylie der Ulvophyceae zu klären (H1), Informationen
über die Architektur und Phylogenomik von Plastidengenomen zu bekommen (H2), die Rolle von
osmotischen Stress (H3) und den Einfluß assoziierter Bakterien (H4) auf die phenotypische Plastizität zu
prüfen.
Bei Interesse bitte direkt bei der Projektleitung melden (Abbildungen anklicken).
online seit 04.05.2023



Girls´ Day am Mondsee, Fotos: S. Wanzenböck
GIRLS´ DAY am Forschungsinstitut in Mondsee
online seit, 27.04.2023
Seeuferreinigung 2023 am Mondsee
Mitarbeiter:innen des Forschungsinstituts bei der Seeuferreinigung 2023 am Mondsee, Fotos: P. Kerschbaumer, S. Mayer
Trotz Starkregens fand am Samstag, 15.04.2023 die zweijährliche Seeuferreinigung am Mondsee statt, bei der neuerlich Vereine und Institutionen aufgerufen wurden tatkräftig bei der Entsorgung von Müll am Seeufer zu helfen. Drei Mitarbeiter:innen des Forschungsinstituts für Limnologie in Mondsee waren heuer mit der Institutszille wieder freiwillig im Einsatz. Bereits seit vielen Jahren unterstützen die Mitarbeiter:innen des Forschungsinstituts diese Aktion durch ihre aktive Teilnahme. Heuer waren alte Autoreifen, Metallschrott und angeschwemmter Kunststoffmüll die Hauptausbeute bei ihrer Reinigungsaktion. Besonders die sensiblen Schilfzonen am Ufer des Sees, die von Wasservögeln und Jungfischen als Kinderstube genutzt werden, aber auch andere unverbaute Uferabschnitte, dienen der aquatischen Tier- und Pflanzenwelt im NATURA 2000 Gebiet als wichtige Rückzugs- und Schutzbereiche. Die Reinhaltung dieser Gebiete von jeglichem Müll dient daher dem Umwelt- und Naturschutz. Dabei sollte das Umweltbewusstsein für intakte Uferregionen nicht auf die Tage der Seeuferreinigung beschränkt werden, auch während des Jahres können aufmerksame Besucher:innen und Nutzer:innen der Region aktiv den angeschwemmten oder mutwillig eingebrachten Müll entsorgen helfen. Sie unterstützten damit das Ökosystem See.
online seit 17.04.2023
Neue Publikation am ILIM/new publication at ILIM:
Weisse T., Scheffel U., Stadler P. (2023). Temperature-dependent resistance to starvation of three contrasting freshwater ciliates,
European Journal of Protistology 88: 125973, https://doi.org/10.1016/j.ejop.2023.125973 
In der Studie wurde die temperaturabhängige Reaktion auf Hunger bei drei unterschiedlichen Süßwasser-Ciliaten (Ciliophora) untersucht. Meseres corlissi (eine zystenbildende, algivore Art) und Glaucomides bromelicola (eine baktivore Art die keine Zysten bilden kann) kommen gemeinsam in Reservoiren von Baumbromelien vor. Die mixotrophe Art Coleps spetai ist in vielen Seen verbreitet. Es wurde angenommen, dass die unterschiedlichen Merkmale und Lebensstrategien dieser Ciliaten ihre Überlebensraten und ihre Temperaturempfindlichkeit unter nahrungsarmen Bedingungen beeinflussen. In Mikrokosmosexperimenten wurden die Sterblichkeitsraten der Organismen, bei verschiedenen Temperaturen und einer Hungerperiode über mehrere Tage, untersucht. Mithilfe eines bildgebenden Durchflusszytometers wurde die Größe der Ciliaten bestimmt und ihre morphologischen und physiologischen Veränderungen als Reaktion auf die Hungersnot gemessen. Bei den zystenbildenden Arten wurde, im Gegensatz zu den nicht zystenbildenden Arten, zwar die höchste Sterblichkeitsrate registriert, durch Zystenbildung könnten diese Arten aber eine langfristige Hungersnot überstehen. Die mixotrophen Arten hatten eine mittlere Sterblichkeitsrate, zeigten jedoch die höchste phänotypische Plastizität als Reaktion auf den Hunger. Ein erheblicher Teil der C. spetai-Population schien von der Hungerphase unbeeinflusst. Dies deutet darauf hin, dass die Endosymbionten den Wirtszellen einige Ressourcen zur Verfügung stellen. Die mittlere Sterblichkeitsrate pro Tag stieg bei allen drei Arten mit der Temperatur um 0,09 °- C1.
Die Open Access Publikation enstand im Rahmen der FWF Projekte P 16796-B06 und P 32714-B .
online seit 11.04.2023
Verabschiedung von Prof. Dr. Arnold Nauwerck

Foto: privat
Am 29.03.2023 nahmen wir in der Evangelischen Kirche Mondsee Abschied von Prof. Dr. Arnold Nauwerck.
Prof. Dr. Arnold Nauwerck, ehemaliger Direktor des Instituts für Limnologie in Mondsee zwischen 1987 und 1997, ist am 8. Februar 2023 verstorben. Als Gewässerforscher hat er schon in den 1960er Jahren mit bahnbrechenden Arbeiten in Schweden internationale Bekanntheit erlangt. Nach weiteren Forschungstätigkeiten in Schweden, Österreich und Kanada kam er schließlich nach Mondsee, leitete das Institut für Limnologie der Österreichischen Akademie der Wissenschaften, lehrte an den Universitäten Salzburg und Innsbruck und machte sich um den internationalen Kurs für Studierende aus Entwicklungsländern verdient. Nach seiner Pensionierung wandte er sich anderen Themen zu und veröffentliche Bücher über die Küche des Klosters Mondsee, über Wirtshausnamen und eine Biographie über J. Grammont, einen Jugendfreund Schillers. Obwohl er die letzten Jahrzehnte relativ zurückgezogen in Scharfling lebte, bleibt er vielen als Forschungskollege, Vorbild, Mentor und Freund in Erinnerung.
Publikationsliste Prof. Dr. Arnold Nauwerck
online seit 03.04.2023
Erfolgreicher MSc-Abschluss in Mondsee
v.l.n.r: Vorsitzender C.-P. Stelzer, Prüfer T. Weisse, S. Seywald und Prüfer J. Wanzenböck.,
Foto: S. Wanzenböck
Mit ihrer Verteidigung "Does connectivity affect phytoplankton species and functional diversity?" schloss Sabrina Seywald am 31.03.2023 ihr Masterstudium erfolgreich am Forschungsinstitut für Limnologie, Mondsee, ab. In der Forschungsgruppe von Thomas Weisse untersuchte sie, ob die hydrologische Konnektivität den Artenreichtum und die funktionelle Vielfalt des Phytoplanktons in Seen beeinflusst. Ihr Ziel war es, den Phytoplanktonarten geeignete funktionelle Merkmale zuzuordnen, um ihre Fressbarkeit für Ciliaten und anderes Mikrozooplankton (hauptsächlich Copepoden und Cladocera) zu charakterisieren. Die Masterarbeit entstand im FWF Projekt "Functional Diversity of Planktonic Ciliates". Wir gratulieren sehr herzlich!
Sabrina Seywald ist bis Ende 2023 im Rahmen des Projekts "Long-Term Ecological Data" (ÖAW, ESFRI/eLTER Data call) weiterhin am Forschungsinstitut in Mondsee beschäftigt (Projektleitung: J. Wanzenböck).
online seit 03.04.2023
Zwei Wissenschaftler aus Mondsee neuerlich unter den 50 führenden Ökologie- und EvolutionswissenschaftlerInnen in Österreich


Martin Dokulil und Thomas Weisse, Fotos: privat und ILIM
Research.com, eine führende akademische Plattform für ForscherInnen, hat kürzlich die Ausgabe 2023 mit den Rankings der 50 führenden WissenschaftlerInnen im Bereich Ökologie und Evolution veröffentlicht. Neuerlich ist das Forschungsinstitut für Limnologie, Mondsee, gleich mit zwei Plätzen vertreten:
Martin Dokulil belegt den 29. und Thomas Weisse den 40. Rang in Österreich.
Das Ranking basiert auf dem D-Index (Discipline H-index), der nur Arbeiten und Zitationswerte für eine untersuchte Disziplin berücksichtigt. Das Ranking umfasst nur führende Wissenschaftler mit einem D-Index von mindestens 30 für akademische Publikationen im Bereich Ökologie und Evolution und wurde anhand von Daten erstellt, die aus mehreren Datenquellen, darunter OpenAlex und CrossRef, kombiniert wurden. Die bibliometrischen Daten für die Auswertung der zitationsbasierten Metriken wurden am 21.12.2022 erfasst.
Wir gratulieren sehr herzlich!
online seit 03.04.2023
Schaffen wir das 6. nachhaltige Entwicklungsziel (SDG) bis 2030?
Weltwassertag, 22.03.2023

Die nachhaltigen Entwicklungsziele (Sustainable Development Goals, SDGs) sollen bis Ende 2030 die Armut beseitigt, die Gleichstellung von Frauen vorgetrieben, die Gesundheitsversorgung verbessert und dem Klimawandel entgegengesteuert werden. Dazu haben sich 193 internationale VetreterInnen aus UN-Staaten geeinigt. Es wurden 17 Ziele und 169 Zielsetzungen der nachhaltigen Entwicklung formuliert, die für alle Staaten weltweit gleichermaßen Gültigkeit haben. Das 6. Entwicklungsziel "Verfügbarkeit und nachhaltige Bewirtschaftung von Wasser und Sanitärversorgung für alle gewährleisten" soll dabei ebenfalls bis 2023 umgesetzt werden.
Der diesjährige Weltwassertag, am 22.03.2023, mit dem Thema "Be the change you want see in the world" fordert alle Menschen auf selbst aktiv zu werden um die Wasser- und Sanitärkrise zu verbessern. Mit einem von UN-Water zur Verfügung gestellten Aktions-Kit, können Gemeinden, Schulen, Firmen, u.v.m. dazu beitragen, dass das 6. Nachhaltigkeitsziel öffentlich thematisiert wird und möglichst viele Menschen zu einer raschen Umsetzung beitragen können.
Mit den Aktions-Kits werden folgende Hilfen zur Verfügung gestellt: (Unterlagen in anderen Sprachen)
Factsheet - Ein kurzer Leitfaden zur Krise und zu den Möglichkeiten, sich zu engagieren. Verfügbar als bearbeitbare Datei
Nachrichten und Karten für soziale Medien - Gebrauchsfertige Inhalte für Ihre sozialen Kanäle
Postkarten - Senden Sie diese an Ihre Kontakte oder verteilen Sie sie bei Veranstaltungen
Poster - Zeigen Sie die Kampagne an und machen Sie auf sie aufmerksam. Erhältlich als bearbeitbare Datei
Banner - Verleihen Sie Ihrem Veranstaltungsraum ein offizielles Branding
Die UN-Wasserkonferenz in New York, am 22. und 23.03.2023, ist die erste Veranstaltung dieser Art seit fast 50 Jahren
(Programm). Hier wird besonderes Augenmerk auf die Zwischenbilanz der UN-Wasserdekade (2018-2028) gelegt.
Als generelles Fazit kann festgehalten werden:
> Es besteht die dringende Notwendigkeit, den Wandel zu beschleunigen - über das "business as usual" hinauszugehen.
> Die neuesten Daten zeigen, dass die Regierungen im Durchschnitt viermal schneller arbeiten müssen, um das SDG 6 rechtzeitig zu erreichen, aber dies ist keine Situation, die ein einzelner Akteur oder eine Gruppe lösen kann. Wasser geht alle an, also müssen alle etwas tun.
Quellen: UN, BM f. europäische und internationale Angelegenehiten, BMUV
online, seit 22.03.2023
Vernetzungsgespräch mit dem Bundesamt für Wasserwirtschaft

v.l.n.r. J. Wanzenböck (ILIM) mit D. Achleitner und P. Strauss (beide BAW) im Uferbereich des ILIM am Mondsee,
Foto: S. Wanzenböck
Am Donnerstag, dem 16.03.2023, fand ein Austausch mit dem Bundesamt für Wasserwirtschaft (BAW) am Forschungsinstitut für Limnologie (ILIM) in Mondsee statt. DI Dr. Peter Strauss (Direktor des BAW) und Mag. Dr. Daniela Achleitner, stv. Leiterin des Instituts für Gewässerökologie und Fischereiwirtschaft in Scharfling, besuchten das ILIM. Besonders gemeinsame Synergien hinsichtlich Langzeitdaten und gemeinsame Projektideen wurden mit Forschungsgruppenleiter Dr. Josef Wanzenböck diskutiert. In der Geschichte des ILIM und des BAW Instituts in Scharfling gibt es schon jahrelange Verbindungen, nicht zuletzt haben mehrere Mitarbeiter:innen des Instituts in Scharfling ihre Master- bzw. Doktorarbeiten am ILIM absolviert. Dabei wurden u.a. Richtlinien entwickelt, die seither im Rahmen der EU-Wasserrahmenrichtlinie (WRRL) zum Einsatz kommen. Für die Vertiefung der Kooperation wurden weitere Vernetzungsgespräche und gemeinsame Seminare vereinbart.
online seit 20.03.2023
Mikroorganismen sind überall
Fotos vom Workshop, credit: S. Wanzenböck
Unser Workshop "Superstarke Mikroorganismen" am 14.03.2023, diesmal an der Internationalen Akademie Traunkirchen, traf bei unseren 18 Jungforscher:innen auf großes Interesse. Neben der Beobachtung von Plankton und Schimmelpilz unter dem Mikroskop konnten die Kinder auch Algen, (fast) unter Laborbedingungen, pipettieren und Hefe beim Wachsen zusehen. Sogar Salzstangerl wurden gebacken und verspeist. Das einstimmige Fazit des Workshops war: "Toll, was man da über Mikroorganismen so alles lernen konnte!"
Im Sommer starten wieder Junge Uni Workshops diesmal zu Aliens im Wasser, Laborabenteuer und den winzigen Planktonorganismen im See, die man unter dem Mikroskop erforschen kann. Alle diese Jungen Uni Veranstaltungen finden am Forschungsinstitut für Limnologie in Mondsee statt. Anmeldung bitte über den Tourismusverband Mondseeland info@mondsee.at oder 06232/2270.
online seit 16.03.2023
Neue Publikation am ILIM/new publication at ILIM:
Weisse T., Scheffel U., Stadler P. (2023). Functional ecology of planctonic ciliates: Measuring mortality rates in response to starvation, J. Eukaryot. Microbiol. 00:e12969, https://doi.org/10.1111/jeu.12969 
Thomas Weisse an der FlowCam, Foto: S. Wanzenböck
In dieser Studie wurde die, durch Hunger verursachte, Sterblichkeitsrate von Ciliaten (Wimpertierchen) untersucht. Dabei wurde die Reaktion der planktischen Ciliaten auf Hunger mit drei verschiedener Methoden festgestellt. Zwei dieser Methoden analysierten die Reaktion der Wimperntierchenpopulation mit Hilfe der herkömmlichen Lichtmikroskopie. Bei einer weiteren Methode kam die bildgebende Zytometrie mit einer FlowCAM zum Einsatz, bei der der relative zelluläre Chlorophyll-a-Gehalt in den Nahrungsvakuolen der Wimpertierchen als Indikator für den Ernährungszustand der Zellen gemessen wurde. Die drei verwendeten Methoden ergaben übereinstimmende Schätzungen der Mortalitätsraten von Wimpertierchen, wobei die FlowCAM Methode erstmals eingesetzt wurde um eine Ciliatenpopulation zu überwachen, die einer Hungersnot ausgesetzt war. Es wäre denkbar, dass transkriptomischen Genexpressionsanalysen von Schlüsselenzymen der Nahrungsaufnahme und Verdauung von Ciliaten und anderen phagotrophen Protisten künftig die optischen Methoden für Ciliaten und andere heterotrophe Protisten ergänzen können. Wie die Bildzytometrie kann auch die Einzelzell-Transkriptomik die phänotypische Plastizität der Räuberpopulation bei Hungersnöten abschätzen.
Die Open Access Publikation wurde vom FWF im Rahmen des Projekts "Funktionelle Diversität planktischer Ciliaten" (P 32714, FG Weisse) finanziert.
online seit, 15.03.2023
Restplätze im WM 22 Ausgewählte Kapitel: Parasitologie (Master Zoologie)
Für Studierende der Universität Innsbruck gibt es noch Restplätze im WM 22 Ausgewählte Kapitel: Parasitologie vom Masterstudium Zoologie. Bei Interesse bitte dem LV Leiter schreiben.
Termine: 5-16.Juni (am Mondsee, OÖ) + Seminar Ende Juni (online)
kostenlose Unterkunft im Forschungsinstitut für Studierende der Uni Innsbruck
online seit 07.03.2023
Restplätze im WM 10 Physiologische Toxikologie und Umwelttoxikologie (Master Zoologie)
Für Studierende der Universität Innsbruck im Master Zoologie: Es gibt noch Restplätze im Modul Physiologische Toxikologie und Umwelttoxikologie. Bei Interesse bitte dem LV Leiter schreiben.
Aquatischer Teil: 22-26. Mai (Mondsee, OÖ) - kostenlose Unterkunft im Forschungsinstitut für Studierende der Uni Innsbruck
Terrestrischer Teil: 15-19. Mai
online seit, 07.03.2023
ECOP-ISOP Kongress 2023 vom 9.-14. Juli in Wien

Zwischen 9. und 14. Juli 2023 findet in Wien der 9. Europäische Kongress für Protistologie (ECOP) statt. Die Tagung wird alle 4 Jahre veranstaltet und findet diesmal als gemeinsame Veranstaltung mit dem Kongress der Internationalen Gesellschaft für Protistologie (ISOP) statt. Als Organisator ist die Deutsche Gesellschaft für Protistiologie (ISOP)/Föderation Europäischer Protistologischer Gesellschaften (FEPS) federführend. Mitarbeiter*innen des Forschungsinstituts für Limnologie sind Teil des Kongress-Organisationsteams.
Die Veranstaltung wird als "Green Event" veranstaltet und findet im Universitätscampus des Alten AKH statt. Die Registrierung der Konferenz ist auf der Konferenzwebseite unter https://ecop-isop2023.univie.ac.at/ möglich. Die ermässigte "Early bird" Anmeldung kann noch bis 17. März 2023 genutzt werden! Die Anmeldung für Vorträge ist noch bis 1. Mai 2023 geöffnet. Die offizielle Konferenzsprache ist Englisch. Für Poster und Nachwuchswissenschafter*innen sind wieder Preise ausgeschrieben. Details finden Sie bitte auf der Tagungswebseite.
online seit, 27.03.2023
Erfolgreicher MSc Abschluss zur Blaualgenforschung

Christoph Kotzorek (2. von links) bei der Defensio , die in hybrider Form abgehalten wurde, screenshot: S. Wanzenböck
Am 22.02.2023 schloss Christoph Kotzorek mit seiner Defensio "Click labelling and In Vitro clicking (CuAAC) of the widespread cyanotoxin Microcystin and the bioactive peptide Anabaenopeptin from cyanobacteria" seine Masterarbeit in der Forschungsgruppe von Rainer Kurmayer ab.
Toxinproduzierende Cyanobakterien (Blaualgen) bilden häufig schädliche Algenblüten, die oft mit hohen Konzentrationen von Microcystinen (MC) und Anabaenopeptinen (AP) verbunden sind, die durch die so genannte nichtribosomale Synthese entstehen. Die Methode der Klick-Chemie ist ein wertvolles Instrument zur Verfolgung und Markierung von Biomolekülen in den
Zellen und wurde zur Untersuchung der subzellulären Lokalisierung dieser Moleküle eingesetzt. Generell gilt, dass
das Verständnis der zellulären Lokalisierung, Speicherung und Funktion von MCs oder APs nach wie vor schwer zu fassen ist aber angesichts ihrer zunehmenden Bedeutung in der aquatischen Umwelt ein wichtiges Forschungsthema darstellt.
In seiner komplexen MSc-Arbeit verwendete Christoph Kotzorek zwei in vitro Klick-Chemie-Experimente zur Kopplung modifizierter MCs und APs an einen säuremodifizierten Alexa-Farbstoff über die sogenannte Kupfer-katalysierte Azid-Alkin-Cycloaddition (CuAAC) Reaktion. Er konnte zeigen, dass CuAAC ein wertvolles Instrument für die subzelluläre Lokalisierung und Biomarkierung von Cyanopeptiden unter Verwendung der Standard-Epifluoreszenzmikroskopie ist. Die bei der Markierung sichtbaren helleren Signale und konsistenteren Ergebnisse für Alexa 488-Azid als für Alexa 405-Azid, waren wahrscheinlich auf die optische Interferenz von AF 405-Azid mit der Autofluoreszenz von Cyanobakterien und/oder dem Antifade-Mittel zurückzuführen. Außerdem wurde eine höhere Variabilität und geringere Konsistenz der Fluoreszenzanalyse von Bildern beobachtet, während auf der Ebene der einzelnen Zelle die Hintergrundfluoreszenz reduziert wurde, was zu besser reproduzierbaren Messungen führte.
Wir gratulieren herzlich!
online seit 23.02.2023
Interesse an einer MSc-Arbeit zum Thema Parasitologie?

online seit, 22.02.2023
Schüler/innen erforschen die Biodiversität von Süßwasserbakterien in Gewässern
Fotos und Probenahmekarte: A. Pitt
Im Sparkling Science Projekt des Institutes Aquirufa: Biodiversität und Ökologie von Süßwasserbakterien gibt es die ersten wissenschaftlichen Ergebnisse. Die Schüler/innen zweier Schulklassen vom BORG Nonntal und dem BRG Schloss Wagrain hatten im Herbst aus selbst gewählten Gewässern Proben genommen und dabei Messungen durchgeführt. Die Proben wurden dann im Klassenzimmer mit den in einem Workshop erlernten Techniken mikrobiologisch bearbeitet. Zur Überraschung für das Projektteam (Alexandra Pitt, Johanna Schmidt, Stefan Lienbacher, Projektleiter Martin Hahn) konnte aus jeder dritten Wasserprobe Bakterienstämme der gesuchten Gattung Aquirufa gewonnen werden. Erste Untersuchungen deuten darauf hin, dass darunter auch neue, noch nicht beschriebene Arten sind. Derzeit werden von 10 Bakterienstämmen die Genome sequenziert, damit lassen sich genauere Analysen durchführen. Die ersten Schulklassen waren schon aus jetziger Sicht durch ihren Einsatz überaus erfolgreich. Im Frühjahr werden weitere vier Klassen in das Projekt einsteigen. Alle Citizen Scientists werden über den gesamten Projektverlauf (bis Herbst 2025) aktiv eingebunden sein. Auch für interessierte Bürger besteht die Möglichkeit zum Mitforschen in Workshops im Institut in Mondsee und in der Auenwerkstatt in der Weitwörther Au im Juni und Herbst 2023. Nähere Informationen gibt es auf der Projektwebseite www.sparklingbacteria.com.
online seit, 21.02.2023
Auf der Suche nach der Elritze im Mondseeland


Schüler*in der Mittelschule Mondsee beim Workshop, credit: S. Wanzenböck
Am 14. Februar 2023 fand der erste Schulworkshop an der Mittelschule Mondsee im Rahmen des Sparkling Science Projekts "Biodiversität der Elritzen in Österreich" statt. Projektmitarbeiter Hans Rund hat über die Lebensweise der Elritze, einer gefährdeten Kleinfischart, und Details zum Projekt informiert. In praktischen Teilen konnten die Schüler:innen selbst Wasser aus drei Standorten, die später auch gemeinsam in den drei Projektjahren beprobt werden, mit Handpumpen filtrieren. So wurde den Schüler:innen die Methode zur Gewinnung der UmweltDNA aus dem Wasser, um die ElritzenDNA nachzuweisen, verständlich gemacht. Die Rundfilter zeigten deutliche, farbliche Unterschiede, die Rotfärbung der Mondsee Probe war auf eine lokale, vorübergehende Blaualgenblüte zurückzuführen, was die Kinder besonders beeindruckte. Die Bewertung der Probenstandorte, biotischen und abiotischen Parameter müssen künftig in einem Protokoll festgehalten werden. Die Bestimmung der verschiedenen Kategorien von Ufer, Substrat, Habitattyp usw. wurde mit den Kindern als Quiz abwechslungsreich vermittelt. Als nächste Aktivität mit der Mittelschule Mondsee sind bereits die Freilandprobenahmen vorgesehen. Das Projekt wird in Kooperation mit dem Naturhistorischen Museum Wien zwischen 2023 und 2025 durchgeführt.
Projekt "Kleine Fische ganz groß-Biodiversität der Elritzen in Österreich"
online seit, 15.02.2023
We look for an
University Assistant – Postdoc (40 hours per week), University of Innsbruck, Research Department for Limnology, Mondsee, Austria, earliest possible start, duration 3 years.
Position:
In this position, you will carry out independent research in the field of aquatic evolutionary ecology by developing a project at the interface of ecology and evolution. The initial idea for the project comes from you, and you will develop it in collaboration with Prof. Seppälä. Collaboration with other research groups at the Research Department for Limnology and at other departments at the University of Innsbruck is encouraged. Possible research fields include, but are not limited to, species interactions, responses to environmental change, evolutionary genetics, and ecosystem functioning. In an ideal case, your project combines different fields.
Qualifications:
- PhD in Biology
- Research experience in Aquatic Ecology and/or Evolutionary Ecology
- Desired: Postdoc experience, publications in high-ranking journals, experience in supervision of students, acquisition of third-party funds and international work experience
- Flexibility and ability to work in a group are essential
For this position we would need a CV, a motivation letter and a brief (max. 2 pages) description of the research idea (e.g., study question, taken approach, possible collaborators).
Location:
The Research Department for Limnology is located on the edge of the Alps in the small town of Mondsee (Upper Austria). The nearest city is Salzburg, which offers history, culture and entertainment at a convenient distance from Mondsee.
Job profile:
The full, legally binding call for application (in German) can be found at www.uibk.ac.at/karriere.
Qualified persons are invited to apply through the Career Portal of the University of Innsbruck (position: BIO-13290).
We are looking forward to receiving your online application by 24th February 2023.
Salary:
The minimum gross salary (stipulated by collective agreement) for this position amounts to € 4.352,00 per month (14 times). Furthermore, the university has numerous attractive offers (https://www.uibk.ac.at/universitaet/zusatzleistungen/).
For more information considering research, please contact Prof. Otto Seppälä: otto.seppaelae@uibk.ac.at
online seit 06.02.2023
Studierende mit fischökologischem Interesse gesucht

online seit 26.01.2023
JUNGE UNI am Mondsee
Unser JUNGE UNI Programm 2023 für den Sommer ist fertig. Wir freuen uns auf viele interessierte Kinder bei unseren Workshops in den Sommerferien. Bitte um rechtzeitige Anmeldung über den Tourismusverband Mondseeland (Ausnahme: Mikroorganismen Workshop am Traunsee - Anmeldung über die Internationale Akademie Traunkirchen).
Auch dieses Jahr gibt es wieder spannende Workshops für Kinder zwischen 7 und 12 Jahren:
- Superstarke Mikroorganismen (am IAT Traunsee), 14.3.2023
- Aliens unter uns (am Forschungsinstitut für Limnologie, Mondsee), 11.7.2023
- 2x Was lebt im See – eine Unterwasserreise mit dem Mikroskop (am Forschungsinstitut für Limnologie, Mondsee), 24.7.2023, 25.7.2023 (Wiederholungstermin)
- 2x CSI Natur- Genetik im Labor (am Forschungsinstitut für Limnologie, Mondsee), 8.8.2023 vormittags, 8.8.2023 nachmittags (Wiederholungstermin)
Wir freuen uns auf eure Anmeldungen!
Details zum Programm 2023
online seit 16.01.2023
Wir stellen ein...
Biologisch Technischer Assistent (m/w/d) in der Forschungsgruppe Evolutionsökologie,
30 Wochenstunden, am Forschungsinstitut für Limnologie, Mondsee, OÖ
Bewerbungsfrist: 14.02.2023
Details siehe https://www.uibk.ac.at/limno/jobs/
online seit: 13.01.2023
Ruhestand


Mit Beginn dieses Jahres gehen zwei langgediente KollegInnen in den wohlverdienten Ruhestand.
Wir wünschen Prof. Dr. Thomas Weisse, FG Leiter Planktonökologie und ehemaliger Institutsleiter, und Dipl. Biol. Ulrike Scheffel alles Gute und bedanken uns für viele gemeinsame und prägende Jahre am Forschungsinstitut.
online, seit 10.01.2023
top ↑






































